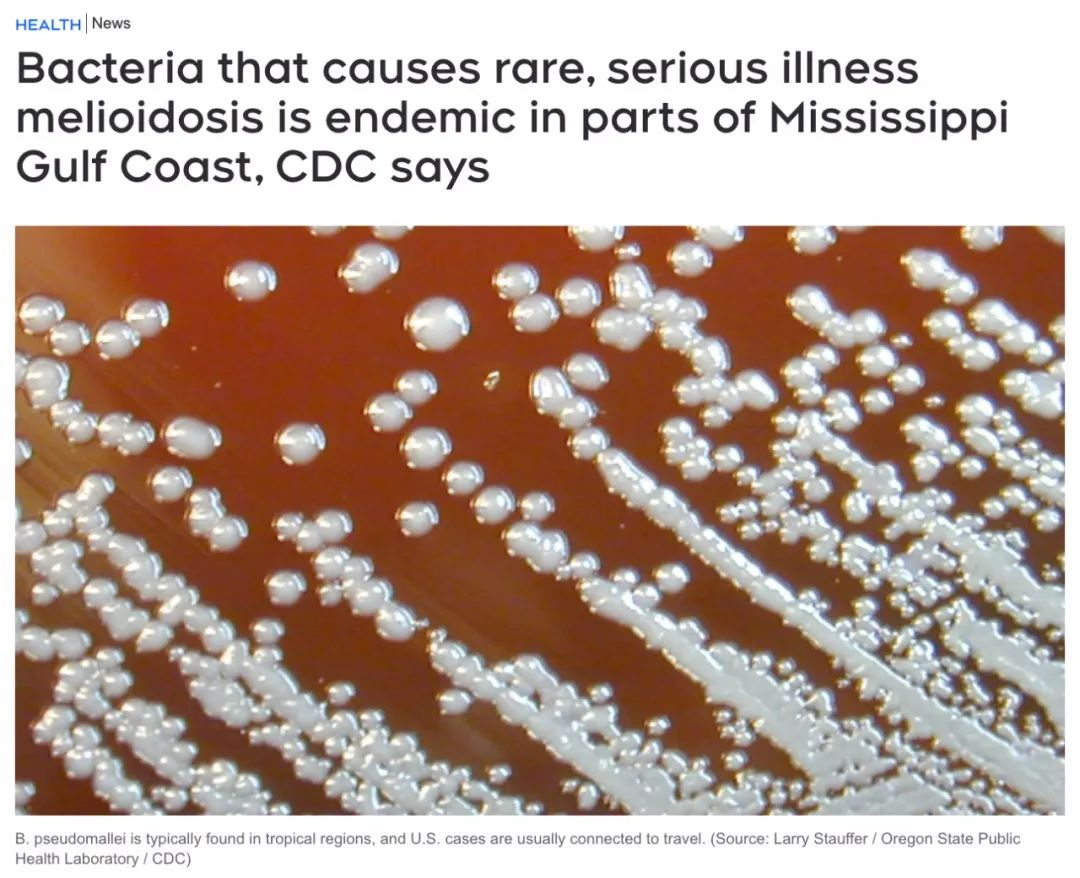

國(guó)際罕見(jiàn)病日|一男子反復(fù)發(fā)熱,一查竟感染了罕見(jiàn)的“泥土病”
39歲的朱先生怎么也沒(méi)想到,在老撾建筑工地工作時(shí),額頭遭不明昆蟲(chóng)叮咬后,他的額部和眼周迅速腫脹,并出現(xiàn)無(wú)明顯誘因的持續(xù)高熱(體溫高達(dá)40℃),伴隨畏寒、寒戰(zhàn)。發(fā)熱期間,還伴有頭暈、咳嗽、咳白色粘痰、食欲不振及嚴(yán)重乏力等全身中毒癥狀。病情急速惡化,患者遂返回國(guó)內(nèi)!
朱先生本身患有2型糖尿病、心律失常及肝功能不全等多種基礎(chǔ)疾病。去年夏季他反復(fù)高熱、寒戰(zhàn),精神狀態(tài)差,緊急入住市人民醫(yī)院感染科。入院檢查發(fā)現(xiàn)病情已迅速進(jìn)展為脾膿腫,診療難度極大。
面對(duì)這一復(fù)雜危重的感染病例,該院感染科團(tuán)隊(duì)高度重視,憑借豐富的臨床經(jīng)驗(yàn)和敏銳的病原學(xué)檢測(cè)意識(shí),在患者入院后第四天,即快速、精準(zhǔn)地明確了致病元兇——類(lèi)鼻疽伯克霍爾德菌。類(lèi)鼻疽是一種病死率高、侵襲性強(qiáng)的傳染病,易導(dǎo)致多部位膿腫形成,病情可在短時(shí)間內(nèi)急劇惡化,引發(fā)感染性休克、呼吸衰竭等致命并發(fā)癥。此例確診為我市首例類(lèi)鼻疽病例。
確診后,該院立即將該病例列為重點(diǎn)監(jiān)護(hù)對(duì)象。鑒于疾病的兇險(xiǎn)性、患者復(fù)雜的基礎(chǔ)狀況以及已出現(xiàn)的脾膿腫并發(fā)癥,感染科迅速組織科室內(nèi)部疑難病例討論,并申請(qǐng)啟動(dòng)全院大會(huì)診,集思廣益,為患者制定最優(yōu)治療方案。治療團(tuán)隊(duì)克服重重困難,實(shí)施了為期一個(gè)月的個(gè)性化、精準(zhǔn)化抗感染及支持治療,并密切監(jiān)測(cè)病情變化。

經(jīng)過(guò)感染科團(tuán)隊(duì)及全院相關(guān)科室的共同努力和精心救治,朱先生病情逐步好轉(zhuǎn)。復(fù)查顯示脾膿腫已完全吸收,各項(xiàng)感染指標(biāo)均恢復(fù)至正常范圍,達(dá)到出院標(biāo)準(zhǔn)。考慮到類(lèi)鼻疽復(fù)發(fā)風(fēng)險(xiǎn)較高,出院前,主管醫(yī)生詳細(xì)向患者及家屬交代了長(zhǎng)期規(guī)范用藥方案及嚴(yán)格的定期隨訪要求。出院之際,朱先生精神飽滿(mǎn),對(duì)醫(yī)護(hù)人員的精湛醫(yī)術(shù)和悉心照護(hù)表達(dá)了由衷的感激:“這次真的感謝你們,是你們給了我第二次生命!”
類(lèi)鼻疽(Melioidosis),俗稱(chēng)泥土病,是由革蘭陰性類(lèi)鼻疽伯克霍爾德菌(以前稱(chēng)假單胞菌)引起感染的熱帶氣候疾病,主要分布在東南亞和澳大利亞北部。
★ 它通過(guò)與受污染的水和土壤直接接觸傳播給人類(lèi)和動(dòng)物。臨床表現(xiàn)包括肺炎、敗血癥和各種器官的局灶性感染。
★ 我國(guó)類(lèi)鼻疽的高發(fā)區(qū)域主要在東南沿海地區(qū)。極端氣候、雨季等因素易誘發(fā)類(lèi)鼻疽疫情。
類(lèi)鼻疽潛伏期沒(méi)有明確定義,可能從1天到數(shù)年不等,但大多數(shù)患者癥狀在暴露后的2-4周內(nèi)出現(xiàn)。
急性肺部感染是最常見(jiàn)的癥狀,表現(xiàn)為輕型到嚴(yán)重的壞死性肺炎。起病可以突然也可逐漸發(fā)生。癥狀有頭痛、厭食、胸膜炎性胸痛或胸部悶痛以及全身肌痛,發(fā)熱通常大于39°C。

類(lèi)鼻疽還存在臨床上高誤診率、高死亡率、高復(fù)發(fā)率的特點(diǎn),具體臨床表現(xiàn)為以下幾個(gè)方面:(1)局部化膿性感染(2)急性肺部感染(3)急性敗血癥型(4)累及中樞神經(jīng)系統(tǒng)時(shí)可出現(xiàn)腦炎或腦膜炎的相應(yīng)癥狀和體征(5)慢性化膿性感染。
大家不必驚慌,目前沒(méi)有發(fā)現(xiàn)類(lèi)鼻疽人傳人的情況。
熱帶地區(qū)居住或旅行的人們,尤其是患有某些慢性病的人,在接觸水或泥土?xí)r,用防水繃帶保護(hù)開(kāi)放性傷口、割傷或燒傷;避免接觸土壤或泥水;不要喝淺井、湖泊、河流、池塘和溪流的水。如果發(fā)現(xiàn)可能的類(lèi)鼻疽癥狀,請(qǐng)立即就醫(yī)。
掃一掃在手機(jī)打開(kāi)當(dāng)前頁(yè)


